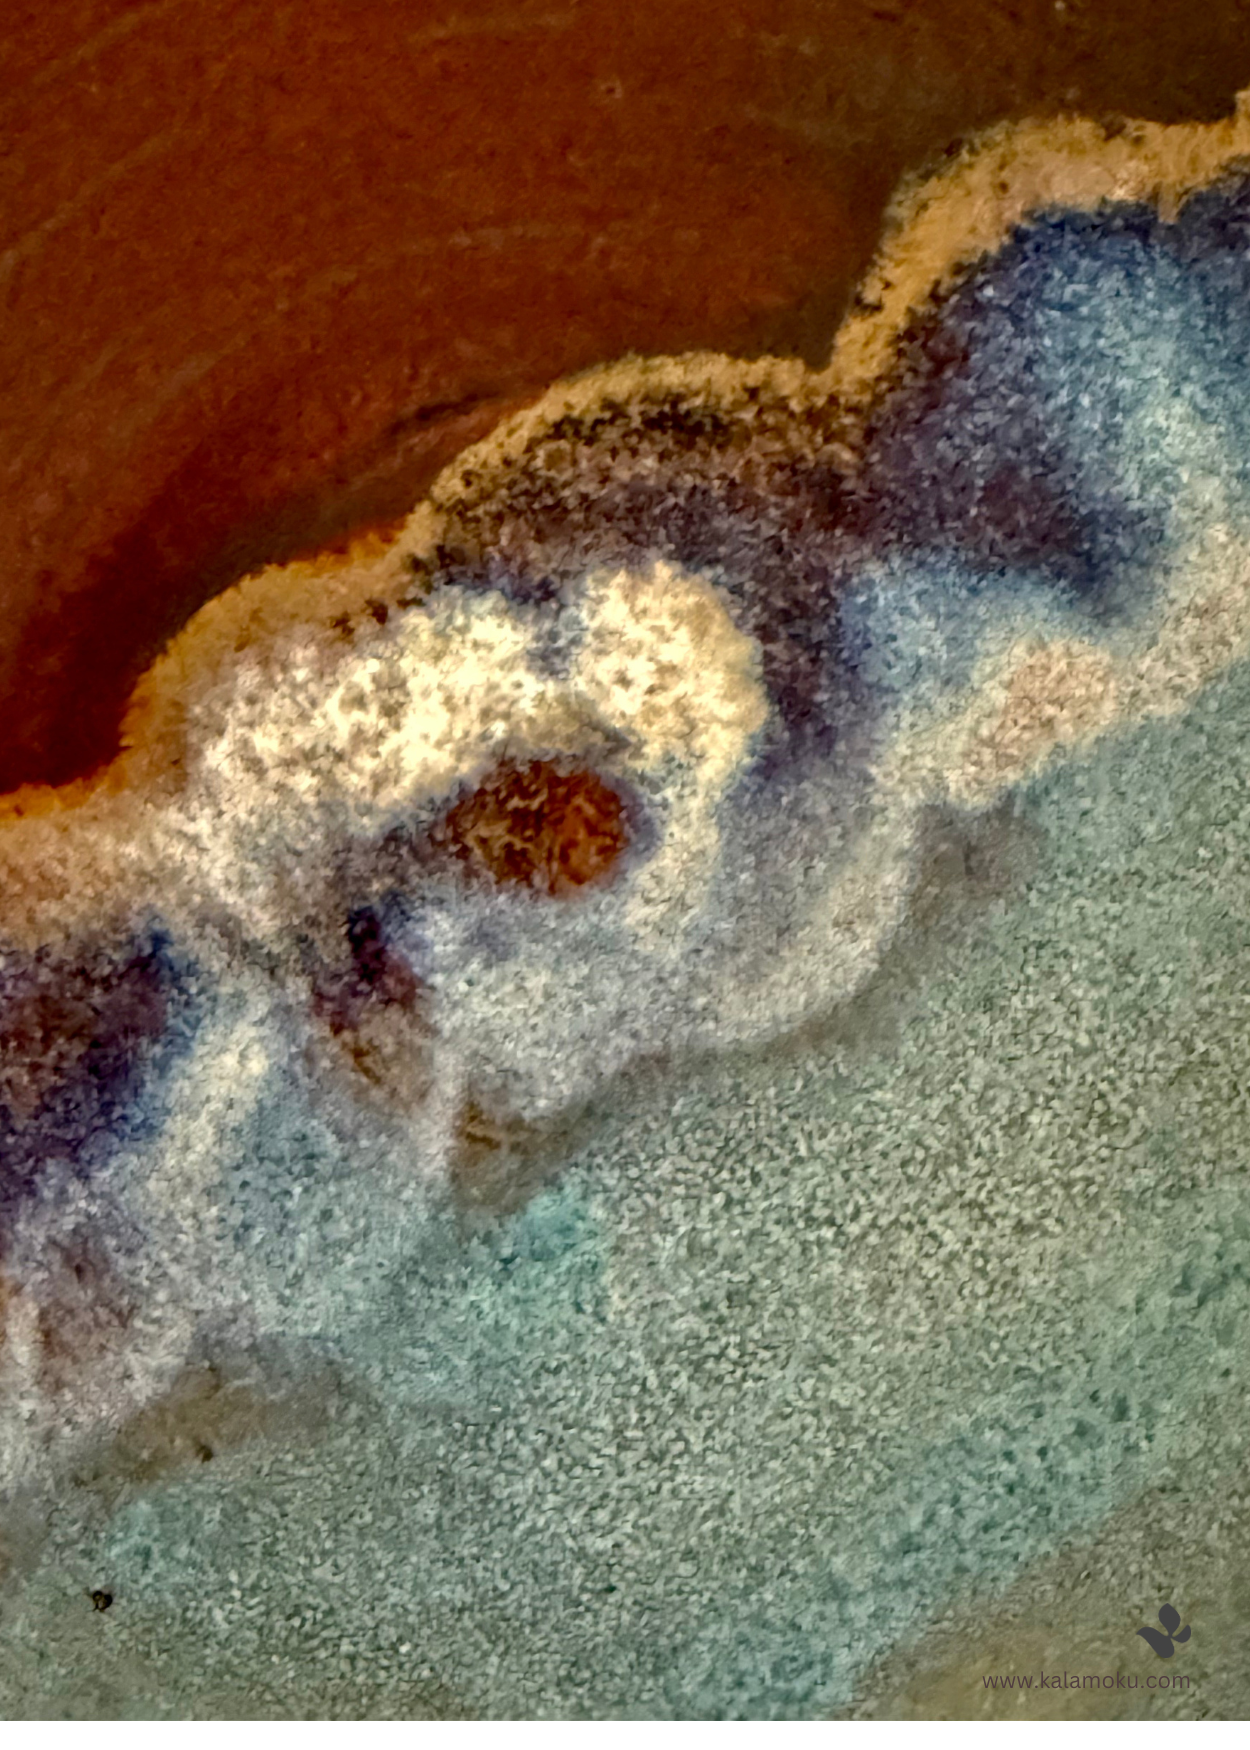

Gallery
Selected items below are available to purchase from Folksy.com
Blue & White Wildflower Vase 3″ £23
CLICK TO BUY ON FOLKSY.COM
Spoon Rest £14
CLICK TO BUY ON FOLKSY.COM

Blue & White Wildflower Vase 9cm

Spoon Rest 12cm

A project title
Client Name

A project title
Client Name